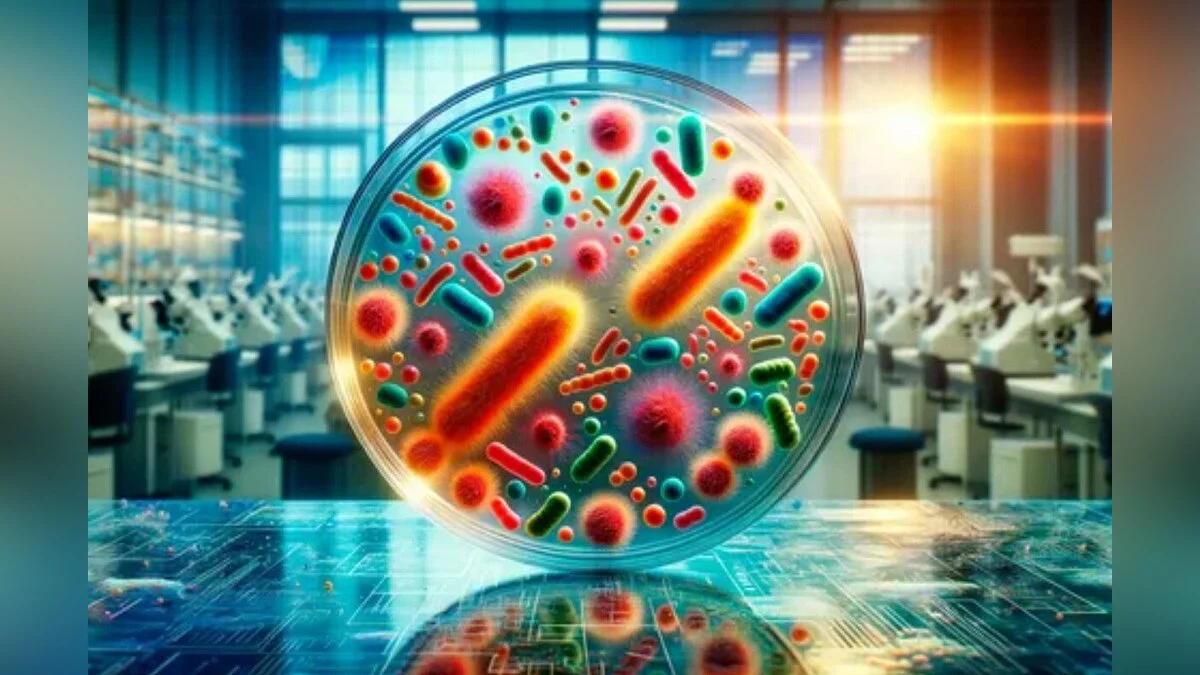

Разработан GPS нового поколения: бактерии расскажут, где вы были
Arkadiy Andrienko
Шведские исследователи разработали уникальный инструмент, использующий микробные отпечатки для отслеживания недавних перемещений человека. Эта система, напоминающая спутниковую навигацию, не ориентируется на GPS-спутники, а определяет географическое происхождение микроорганизмов, чтобы узнать, где побывал человек — на пляже, в парке или в метро.
Каждое место на Земле обладает уникальным микробным составом, или микробиомом, который служит «отпечатком» данной локации. Исследователи создали алгоритм Microbiome Geographic Population Structure (mGPS), использующий искусственный интеллект для анализа этих микробных отпечатков и их привязки к определенным локациям.
В системе mGPS используется информация о бактериальных сообществах, обнаруженных в городах, водоемах и почве по всему миру. Для тестирования было собрано более 4000 образцов из общественного транспорта, городских территорий и морской воды, что позволило с точностью до 92% идентифицировать географические источники данных образцов.
Эксперименты показали, что система способна точно указывать место в пределах одного города: в Гонконге mGPS определил конкретные станции метро, а в Нью-Йорке различил микробиом поручней на расстоянии всего одного метра. Эта технология открывает новые возможности в судебной медицине, позволяя детально отслеживать перемещения подозреваемых, а также в медицине и эпидемиологии — с её помощью можно исследовать распространение инфекций и источники резистентных к антибиотикам бактерий.
Эксперты считают, что этот подход откроет новую главу в криминалистике и научных исследованиях, изменив подход к изучению перемещений людей и распространению заболеваний.
-
Ученые разработали материал, предотвращающий возгорание аккумуляторов -
Ученые представили экран нового поколения, управляемый магнитами -
Ученые выяснили, что женщины-геймеры отдают предпочтение сексуализированным персонажам -
Ученые создали имплант, который способен полностью восстановить зрение -
Датские ученые создают революционные искусственные мышечные волокна